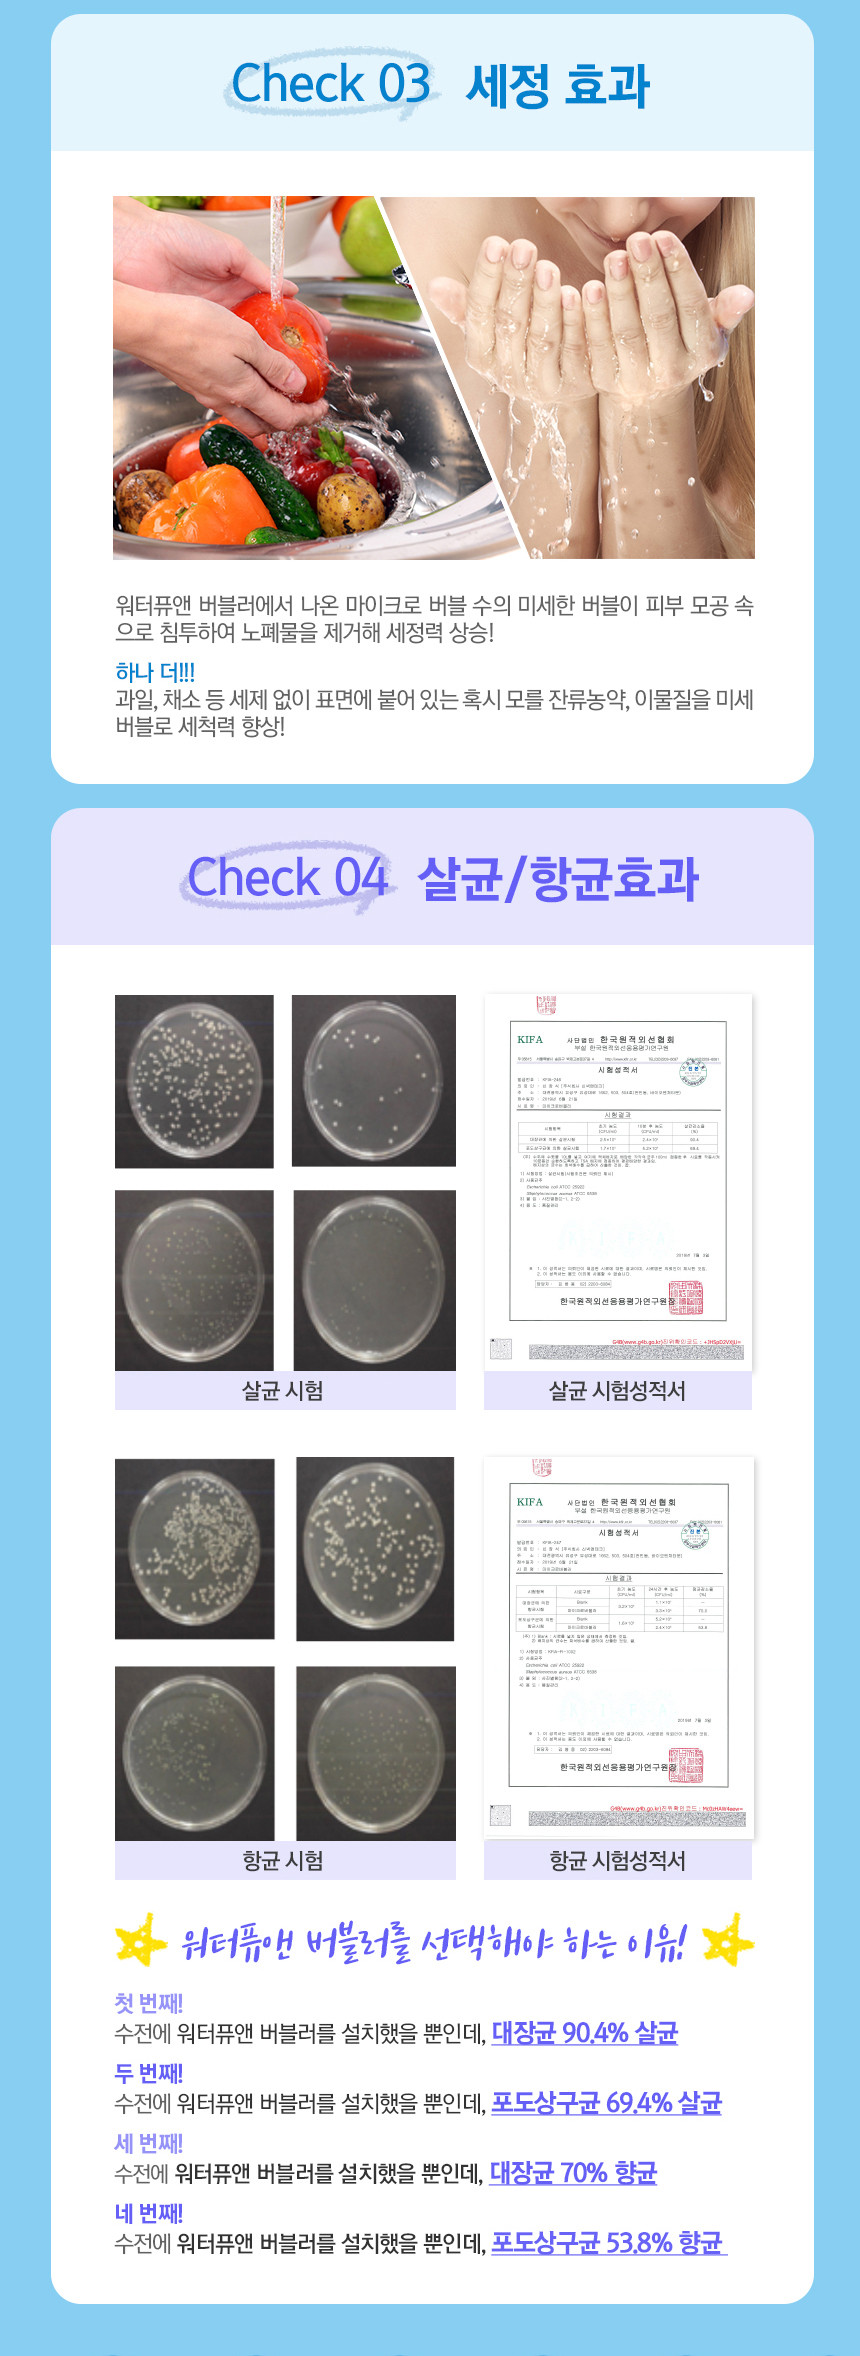

붉은 수돗물 사태
2019년 여름,
인천 서구에서 갑작스러운 붉은 수돗물 사태가 발생했습니다.

이와 관련하여,
원인이 되었던 수돗물 공급체계를 변경하는 "수계 전환"을 단계적으로 진행한다고 하며
(좀 더 자세한 뉴스 내용은 아래 링크 참고)
https://www.yna.co.kr/view/AKR20201008079700065?input=1195m
'붉은 수돗물' 사태 겪은 인천, 대대적 수계전환 앞두고 '조심' | 연합뉴스
'붉은 수돗물' 사태 겪은 인천, 대대적 수계전환 앞두고 '조심', 홍현기기자, 사회뉴스 (송고시간 2020-10-11 08:30)
www.yna.co.kr
원인이 해결하는 듯했으나,
올해 2020년 또 다른 유충 사건이 전국 각지에서 터져 나왔습니다.
경기, 부산, 서울 등 점점 확산으로
전국 각지에서 수돗물 관련하여 다양 한 문제가 생겨났습니다.

이런 일들을 계기로 가정집에서는
수돗물 필터가 유행을 하기 시작합니다.
[ 실제로 인천에 살고 있던 제 주변 지인은 이런 일도 겪은 적이 있습니다. ]

물고기 키우는 것을 취미로 시작했는데, 자꾸 물고기가 죽었다고 합니다.
그래서 본인이 관리 소홀이나 물고기를 너무 못 키우는 것 같아,
어항이나 여과기 등등 최신식 장비를 구매하여
전문가 수준으로 물고기를 키운 적이 있다고 합니다.
하지만 그래도 물고기는 얼마 못가 죽었고,
나와는 맞지 않는 것 같아 끝내 취미를 포기합니다.
그 이후,
이사를 가게 되었고,
무언가에 삘이 꽂혀 다시 물고기를 키우는 취미를 시작했다고 합니다.
그랬더니, 특별히 많은 관심을 주지 않아도 물고기가 죽는 일은 없었다고 합니다.
이때 지인은 수돗물이 문제가 있었고나 라고 깨달은 적이 있다고 하였습니다.
이처럼 눈으로 보기에 이상이 없어 보이는 물인데도
수질적으로 문제가 많을 수 있다는 것을 지인 덕에 처음 알게 된 계기였습니다.
저도 한 아파트에서 어린 시절부터 엄청 오래 살았고 (25년)
어린 시절부터 가슴에 여드름이 생겼었습니다.
이 말을 듣고, 30살이 되어서야 샤워기 필터를 구매하여 사기 시작했네요.
아무튼,
이런 일을 계기로 물에 대해 조금 신경을 쓰게 되었고
저 뿐만 아니라 전국 사람들에게 대 유행이 생겨났던 것 같습니다.
사실 이런 일이 발생되지 않았더라도,
저희 아파트는 종종 수도관 청소를 합니다.
청소 직후에는 녹물이 나올 수 있다고 당부의 방송을 하곤 합니다.
이런 내용을 보았을 때 확실히 필터 하나쯤 달아놓는 것이 정신 건강에 좋은 것 같습니다.

마이크로 버블 세면대 필터
물과 관련된 정말
다양~~~~한 상품들이 많이 출시가 되었습니다.
녹물 제거 필터, 비타민 필터, 온도 인식 LED 필터, 살균 LED 필터 등등등
그중에서도 정말 상상도 못했던,
특별한 필터가 출시되어 한번 소개해보고자 합니다!!

네 그렇습니다.
마이크로 버블 발생
음이온 효과
녹물 & 이물질 제거
절수 효과
세정력 상승
살균 및 항균 효과
다른 세면대 필터와는 다른 특이한 효과가 있었습니다.
바로
마이크로 버블 발생

이렇게 정말 특별하고 엄청난 장점이 있는 제품이 있었습니다.
그럼 실제 사용하는 모습은 어떠한지
제가 직접 사용해봤습니다!!

워터퓨앤 버블러 & 버블탭

집으로 상자 하나가 띡하고 도착하였습니다.

역시 상자를 개봉하는 순간이 가장 행복합니다.


베일에 싸여있던 아이가 드디어 세상 밖으로 나왔습니다.

짜잔~~~~~~~~
네,
위에서부터 버블탭 3개
아래는 버블러 3개
입니다.
엥?
갑자기 버블러, 버블탭이 뭐냐구요..?



왼쪽이 버블탭, 오른쪽이 버블러 입니다.
버블탭과 버블러는 필터로써는 같은 기능을 하는 아이이지만,
버블탭은 기존 세면대에서 사용되었던
기본 포멀캡의 필터 부분을 교체하여 사용되는 것이고
버블러는 포멀캡 사용 없이 통째로 교체하는 제품입니다.
요약하자면
버블탭은 크기가 작고, 가격이 조금 더 저렴한 장점이 있고
버블러는 크기가 크지만 포인트를 줄 수 있는 장점이 있습니다.
자세한 교체 내용은 좀 더 아래에서 확인해봅시다.



버블탭 상자입니다.



이번엔 버블러 상자입니다.
버블탭과 버블러의 상자의 글은 모두 일치하였고
버블러 상자에만 다음과 같은 문장이 딱 하나 추가로 적혀있었습니다.
"워터퓨앤 버블러 나사선 외경 24mm, 1피치입니다."

왼쪽 - 버블탭 오른쪽 - 버블러


버블러 사용 설명서


버블탭 사용 설명서
아래에서 설명서 대로 제가 손수 다 보여드리겠습니다.


왼쪽이 물이 들어가는 부분(위쪽)
오른쪽이 물이 나오는 부분(아래쪽)
입니다.


6상자의 정체는 바로 이렇습니다!
색깔 별로 나열해 봤습니다.
모두 다른 색상입니다!!

왼쪽부터 샴페인, 실버, 블랙 색상입니다.

이외 화이트 색상이 더 존재합니다!

버블탭의 색상입니다. 여기에 추가로 화이트 색상이 하나 더 있습니다.


버블탭과 버블러의 확대 영상입니다.
아쉽게도 분해를 할 수 없는 구조로 되어 있었습니다.
저한테는 아쉬웠지만 사용자 입자에서는 그만큼 튼튼하다는 의미입니다.
확대를 해서 보니 촘촘한 망으로 되어 있었고
저 내부가 가장 궁금하긴 하지만
필터 역할로 믿음직해 보입니다.
이제 실제로 교체하러 가봅시다!!

다이소에서 판매하는 멍키스패너입니다.
가격은 3천 원 정도로 기억합니다.


실제 세면대에서 분리해보니
무자비하게 더럽습니다.
기본적인 포멀캡은 정말 필터의 기능이 1도 없어 보이는군요..


아랫면, 윗면



이러한 기본 포멀캡을 단계별로 분리하면 마지막 사진과 같은 모습이 됩니다.


버블탭의 사용법
이제 이해되셨나요!?
마지막까지 분리된 링에
버블탭을 쏙 하고 넣어주시면 됩니다!!
분리부터 장착까지 영상으로 한번더!


저는 실제로 물과 관련된 작업을 할 때 테프론 테이프를 꼭 감아줍니다.
아무리 잘 만든 그 어떤 제품도 누수는 존재하였고,
그 누수를 막는 기능을 하는 것이 바로 테프론 테이프입니다.
오른쪽 사진과 같이 다이소에서는 2개의 천 원에 "나사 테이프"라는 이름으로 판매하고 있습니다.
[ 장착 영상 ]
버블탭과 버블러 장착 영상입니다.
버블탭 장착시 기본 포멀캡에 기스가 잘 생기니 참고하세요!


확실히 디자인적으로 호불호가 갈릴 것 같습니다.
저 역시도 처음에 버블러같은 큰 아이로 교체하면서
뭔가 모를 크기가 큰 것에 대한 불편한 느낌이 들었습니다.
물론 적응하면 또 편해졌지만 뭔가 큰 게 하나 생긴 느낌입니다.
그래서 버블탭이라는 아이가 생겨난 것 같습니다.
실제로 마이크로 버블이 무엇인지 실험 영상을 확인해보겠습니다.
확실히 투명함의 정도가 달랐습니다.
버블탭과 버블러의 마이크로 버블 생성에 대한 성능 차이까지
확인해보니 큰 차이는 없어 보입니다.
마이크로 버블이 톡톡 터지는 소리입니다.
이어폰을 끼고 크게 들어보세요.
(물이 한방울씩 뚝뚝 떨어지는 소리는 양해바랍니다. ㅠㅠ)
전체 색상에 대한 비교샷입니다.






저는 버블러는 샴페인 색상이 가장 마음에 들었고,
버블탭은 블랙 색상이 마음에 들었습니다.
버블러는 크기가 크기 때문에 기존 수전과 통일되는 색상일수록 자연스러워 보였고,
버블탭은 크기가 작기 때문에 포인트가 될 수 있는 다른 색상이 들어가야 티가 나면서 더 괜찮아 보였습니다.

총평
저는 사실 이 워터탭을 교체하기 이전에
LED 살균 워터탭을 사용하였었습니다.



사진을 보시면 아시겠지만,
필터가 얇은 천 같은 것은 그 위에 덮는 형태였고 주변 틈이 존재합니다.
이 부분 때문에 사실 필터의 기능을 할 수는 있을까 의문이었습니다.
게다가 1~2달 사용하니 LED 등이 금방 고장이 나더군요..
(구매 측에 문의하여 새로 교체할 수 있었으나 또 한 두 달 정도 만에 고장이 났고,
내부 부품을 분석해보니,
수압으로 인하여 내부 플라스틱 부품이 깨지면서 고장.
부품만 또다시 교체. 이후 또 한 달 만에 고장.
결국 최대 수명 한 달~두 달로 판단하게 되었습니다.)
그래서 금방 사용하지 못하게 되어 기본 탭을 사용하고 있었습니다.
하지만 이 워터퓨앤 버블러 제품은 우선 굉장히 튼튼하였고
쉽게 고장 날 일은 없어 보여서 정말 만족스러웠습니다.
또한 다른 제품들은 눈에 보이는 효과가 특별히 존재하지 않아 아쉬웠지만
이 제품의 경우는 마이크로 버블이 확연하게 다른 물을 뽑아주니
그 부분 또한 만족스러웠습니다.
마이크로라는 아주 작은 단위를 관리하니,
미세한 불순물을 제거해 줄 것 같은 심리까지 준다고 해야 할까요.
아쉬운 부분이 있다면,
소비자들의 입장을 고려하여
아주 약간의 테프로 테이프를 제공하거나,
1회용 스패너를 함께 동봉해 보내주면 좋지 않을까 생각이 듭니다.
그 외에 제품 자제로는 마감이나 디자인 부분(도금) 등은 너무 마음에 들었습니다.
조금 욕심이 있다면 지금 이 상태에 LED 등까지 달리면 최고의 제품이 나올 것 같습니다만,
그러면 엄청 커지겠죠...? 하하..
아무튼 버블러를 통해 나온 물을 문질 문질 하면 뭔가 모를
버블들이 느껴지는 듯한 느낌이 들었습니다.
이러한 마이크로 버블이 모공 속을 청소해 준다고 하니
미용이나 피부에 관심이 많은 분들에게는 정말 기분좋은 소식이 아닐까 합니다.
게다가 미세입자 덕에 주방에서 과일 등을 씻을때 사용할 경우
세정력이 증가된다고 하니 여러군대 설치하여 사용할 예정입니다.
이 물로 양치해도 잘 씻겨 내려갈 것 같네요.. ㅎㅎㅎ


오래간만에 만족하는 제품 정말 잘 사용하겠습니다.
https://smartstore.naver.com/waterpure/products/5170189142
[세면대필터]워터퓨앤 버블러 : 워터퓨앤
[워터퓨앤] 순수한 물로 만들기 위해 워터퓨앤의 샤워기, 필터, 버블러, 버블탭을 준비했습니다.
smartstore.naver.com
https://smartstore.naver.com/waterpure/products/5170175268
[주방용필터]워터퓨앤 버블탭 : 워터퓨앤
[워터퓨앤] 순수한 물로 만들기 위해 워터퓨앤의 샤워기, 필터, 버블러, 버블탭을 준비했습니다.
smartstore.naver.com

'취미 > 리뷰' 카테고리의 다른 글
| 유튜브 댓글 랜덤 추첨 한국 사이트 두둥! (0) | 2020.12.08 |
|---|---|
| 땅따먹기 컨셉의 무료 홍보 광고 사이트 네모랜드(NEMO LAND) (1) | 2020.11.27 |
| 페로몬 향수?? 남자의 고급 스러운 향수?? 남자 향수?? (0) | 2020.11.09 |
| 다이소 녹 제거제 VS 콜라 VS 치약 녹 제거 충격 실험 (2) | 2020.11.04 |
| 아이폰 배터리 자가 수리 과정. DIY 아이폰 X 편 (0) | 2020.11.01 |